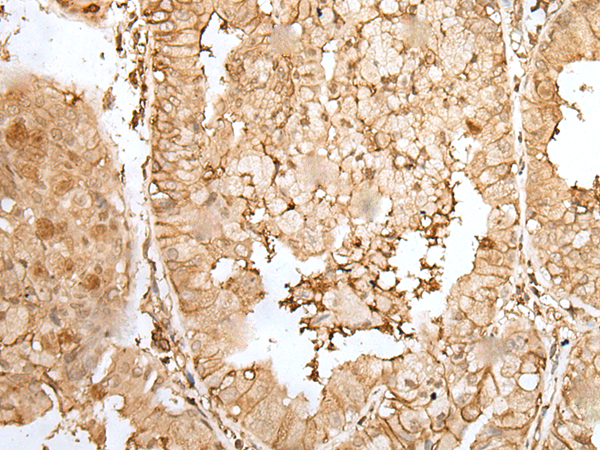

中文名稱:兔抗ZNF213多克隆抗體
|
Background: |
C2H2 zinc finger proteins, such as ZNF213, have bipartite structures in which one domain binds DNA or RNA and the other modulates target gene expression. |
|
Applications: |
ELISA, IHC |
|
Name of antibody: |
ZNF213 |
|
Immunogen: |
Fusion protein of human ZNF213 |
|
Full name: |
zinc finger protein 213 |
|
Synonyms: |
CR53; ZSCAN53; ZKSCAN21 |
|
SwissProt: |
O14771 |
|
ELISA Recommended dilution: |
5000-10000 |
|
IHC positive control: |
Human liver cancer and human esophagus cancer |
|
IHC Recommend dilution: |
25-100 |

購物車
購物車 幫助
幫助
 021-54845833/15800441009
021-54845833/15800441009
